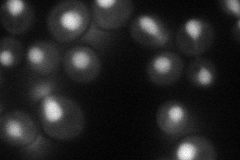
YDR088C
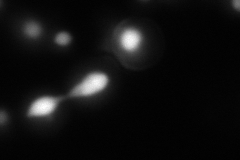
YDR088C
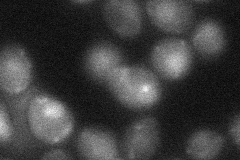
YDR088C
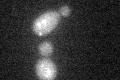
YDR088C
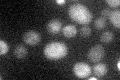
YDR088C

View description
RNA splicing factor, required for ATP-independent portion of 2nd catalytic step of spliceosomal RNA splicing; interacts with Prp18p; contains zinc knuckle domain
Localization:
Intensity:
Fold change:
Significance:
-
C’ GFP library in SD

below threshold15.14 -
N' NOP1pr-GFP in SD
nucleus48.7405 -
N' TEF2pr-mCherry in SD
nucleus147.996 -
N' NATIVEpr-GFP in SD

nucleus25.1189 -
N' TEF2pr-VC and Cyto-VN in SD
nucleus27.8858 -
C’ GFP library in SD+DTT
cytosol16.241.07No -
C’ GFP library in SD+H2O2

cytosol18.551.22No -
C’ GFP library in Starvation Media
cytosol28.011.84No -
C’ GFP library on the background of Pup2-DaMP

below threshold -
C’ GFP library on the background of CCT mutant

below threshold16.85161.11244No
